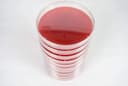
Thumbnail 2

We remain fully operational. Our teams are working around the clock to ensure your deliveries continue safely.
Customer Services
Copyright © 2025 Desertcart Holdings Limited

Our Red Blood Agar (RBA) plates are TSA with 5% defibrinated Sheep Blood and the main application is for the isolation and cultivation of a variety of fastidious microorganisms, to detect hemolytic activity, and to perform CAMP tests. Our blood agar is an enriched, bacterial growth medium that encourages the growth of bacteria, such as streptococci, that otherwise wouldn’t grow on ordinary growth media. Provides better results on E. Coli and Streptococcus Pneumoniae. Certain bacterial species produce extracellular enzymes that lyse red blood cells in the blood agar (hemolysis). These hemolysin radially diffuses outwards from the colony (or colonies) causing complete or partial destruction of the red cells in the medium and complete denaturation of hemoglobin within the cells to colorless products.
Trustpilot
3 weeks ago
2 months ago
1 month ago
1 month ago